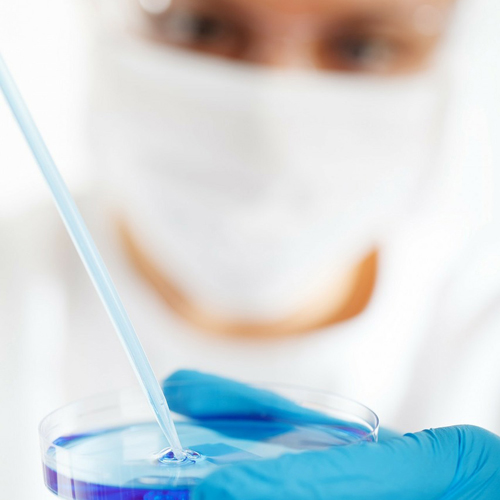

GÜVENLİK

Üretim
Los Deline ™ üretimi için, şirket üreticisi BIOTRH s.r.o. BIOMEDICA spol'un üretim tesislerini kullanır. Üretim Çek Cumhuriyeti’nde gerçekleştirilir.
Ürün en sıkı sterilizasyon ve kontrol yöntemleri altında üretilmektedir. Piyasaya çıkmadan önce ürünün sterilizasyon, paketleme ve güvenlik testlerine sıkı sıkıya bağlılığı bağımsız laboratuarlar ve imalatçı tarafından tarafından gerçekleştirilir.
Şirketimizin kapsamlı güvenlik felsefesi, hammadde seçiminden nihai üretime, depolamadan ürünün nakliyesine kadar tüm proses zinciri boyunca uygulanır.
Ürünlerimiz son teknoloji tesislerde üretilmekte ve üretimin tüm aşamalarında en sıkı kalite ve güvenlik kontrollerine tabi tutularak, ilgili tüm uluslararası standart ve yönetmeliklere uygun olarak belgelendirilmektedir.
Standartlar ve Belgelendirme
Los Deline ™, AB'nin en yüksek kalite standartlarına göre üretilmiştir.
İnsan yumuşak doku endoprotezi Los Deline ™ hidrofilik jel implant aşağıdaki sertifikalara sahiptir :
EC SERTİFİKASI
Tıbbi Cihazlar Tam Kalite Güvence Sistemine İlişkin 93/42 / EEC sayılı direktifin ek II'sine göre
No. : 2195-MED-1820101
EC TASARIMI MUAYENE BELGESİ
No. : 2195-MED-1820101-D01
ISO 13485: 2003 (TIBBİ CİHAZLAR KALİTE YÖNETİM SİSTEMİ)
No. : 31820101

Biyouyumluluk
Los Deline ™ ürünü, ISO 10993: 2009'a (Tıbbi cihazların biyolojik değerlendirmesi) uygundur. Bu standart, cihazları invazivliği ve hasta teması süresi açısından tanımlar. Bu, olası toksikolojik etkilerin çeşitli kategorilerinin biyolojik güvenliğinin dikkate alındığı anlamına gelir. Materyal, canlı bir sistem veya dokudan lokal veya sistemik bir yanıt ortaya çıkarmamakla biyolojik olarak uyumludur.
Yapılan cihaz güvenliği / biyouyumluluk değerlendirmesi listesi:
- Sitotoksisite Testi (ISO 10993-5)
- Duyarlılık Testi (ISO 10993-10)
- İritasyon Testi (ISO 10993-10)
- Sistemik Toksisite Testi (ISO 10993-11)
- Genotoksisite / Mutajenite Testi (ISO 10993-3)
- İmplantasyon Testi (ISO 10993-6)